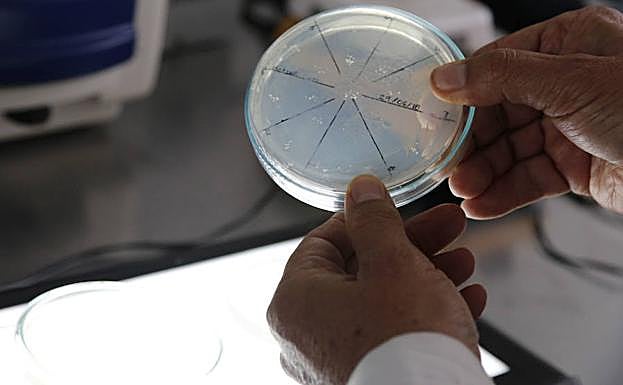
Mapean por primera vez los árboles genealógicos de las células cancerosas de la leucemia

Mapean por primera vez los árboles genealógicos de las células cancerosas de la leucemia
El objetivo es comprender cómo el tumor responde al nuevo medicamento Enasidenib
europa press
Madrid
Lunes, 16 de julio 2018, 16:18
Investigadores del campus del cáncer Gustave Roussy e Inserm en París (Francia), la Unidad de Hematología Molecular del MRC y el Instituto de Medicina Molecular MRC Weatherall de la Universidad de Oxford (Reino Unido), Memorial Sloan Kettering Cancer Center (Estados Unidos) y Celgene han mapeado por primera vez los árboles genealógicos de las células cancerosas de la leucemia mieloide aguda, con el fin de comprender cómo el tumor puede responder al nuevo medicamento Enasidenib.
«Enasidenib es un importante nuevo tratamiento. Sin embargo, los estudios iniciales no mostraron qué células de la leucemia mieloide aguda respondieron a Enasidenib y comenzaron a diferenciarse otra vez. Tampoco estaba claro cómo las células se vuelven resistentes a la terapia», han dicho los investigadores, cuyo trabajo ha sido publicado en la revista 'Nature Medicine'.
Usando muestras de 37 pacientes que respondieron a Enasidenib en un anterior ensayo, el equipo analizó marcadores en la superficie de las células de la médula ósea para identificar las diferentes poblaciones de células de la médula ósea, desde las células inmaduras e indiferenciadas, llamadas células progenitoras, hasta células maduras y diferenciadas.
«Se puede imaginar la médula ósea como una línea de montaje que constantemente necesita producir células sanguíneas maduras. En un paciente antes del tratamiento, esta línea de montaje se bloquea. Mediante técnicas especializadas, estudiamos las células de la médula ósea de los pacientes para descubrir cómo se bloquea la línea de ensamblaje de la médula ósea y cómo Enasidenib ayuda a promover la diferenciación para desbloquear la línea de ensamblaje», han argumentado los científicos.
Familias con mutaciones genéticas
Como esta enfermedad está causada por errores en la secuencia de ADN, o mutaciones, en las células sanguíneas, el equipo estudió la composición genética de las células del tumor, descubriendo que las de un mismo paciente se pueden agrupar en familias que comparten mutaciones genéticas, llamadas clones. Las células que pertenecen al mismo clon o familia, provienen de la misma célula ancestral.
«Cuando un paciente con leucemia mieloide aguda tiene una prueba de médula ósea, estamos tomando una instantánea del árbol genealógico de las células leucémicas. A medida que tratamos la enfermedad, hay cambios en la dinámica familiar ya que algunos clones morirán y otros crecerán. En cada cáncer hay varias familias o clones de células cancerosas. En este tumor pudimos ver cómo respondían a enasidenib», han explicado los expertos.
Para ello, utilizaron técnicas para estudiar las mutaciones genéticas célula por célula y reconstruyeron el árbol genealógico de la leucemia mieloide aguda de un paciente. A continuación, rastrearon los cambios en la familia de las células a medida que respondían a Enasidenib y a medida que los pacientes perdían la respuesta al tratamiento.
«Hemos proporcionado pruebas genéticas de que Enasidenib fue capaz de diferenciar las células cancerosas para restaurar algunas de sus funciones normales, incluso aunque todavía contenían la mutación IDH2. Esto es importante porque, a menos que podamos rastrear estos clones, no sabemos si las células maduras en un paciente provienen de células normales después de que se hayan eliminado todas las células cancerosas o de células leucémicas que ahora es capaz de madurar», han apostillado.
El cáncer volvió en casi todos los pacientes en el ensayo clínico, y el equipo pudo demostrar por primera vez que las células leucémicas dejan de responder a Enasidenib cuando algunos de los clones desarrollan mutaciones adicionales. Estos nuevos subclones son resistentes a enasidenib, proporcionando pistas sobre el mecanismo de resistencia a los medicamentos y lo que podría servir para diseñar futuros ensayos de terapia para superar la resistencia a la terapia.
También puede significar que enasidenib necesita combinarse con otros medicamentos contra el cáncer para prevenir una recaída, y los ensayos clínicos ya han comenzado a investigar si los pacientes responden a estas combinaciones, durante cuánto tiempo y si es probable que recaigan.